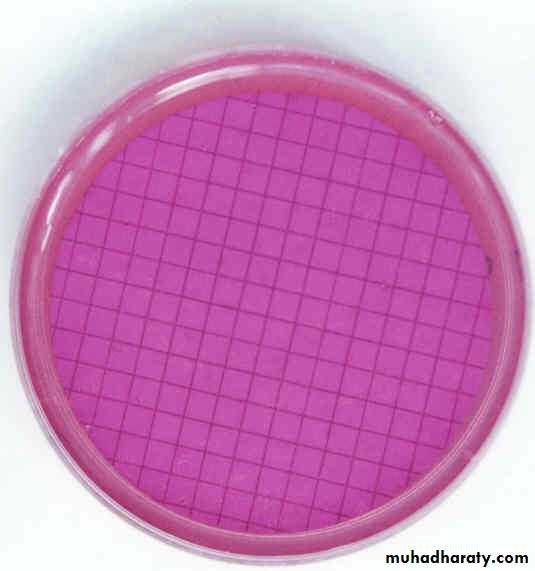
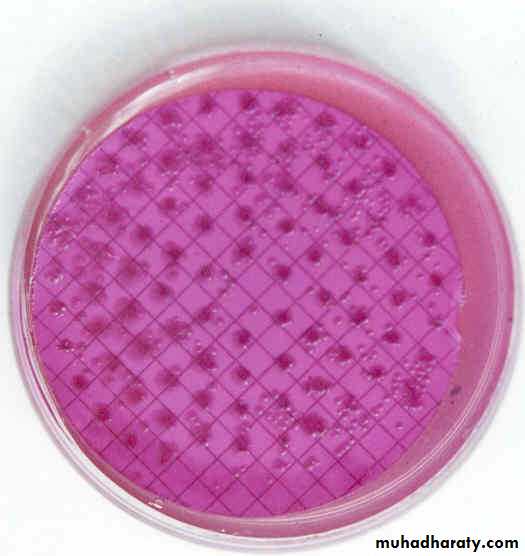
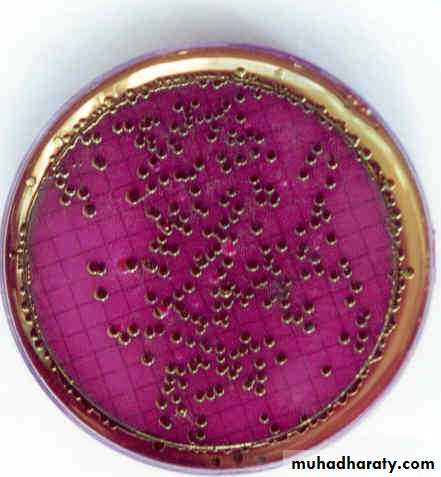
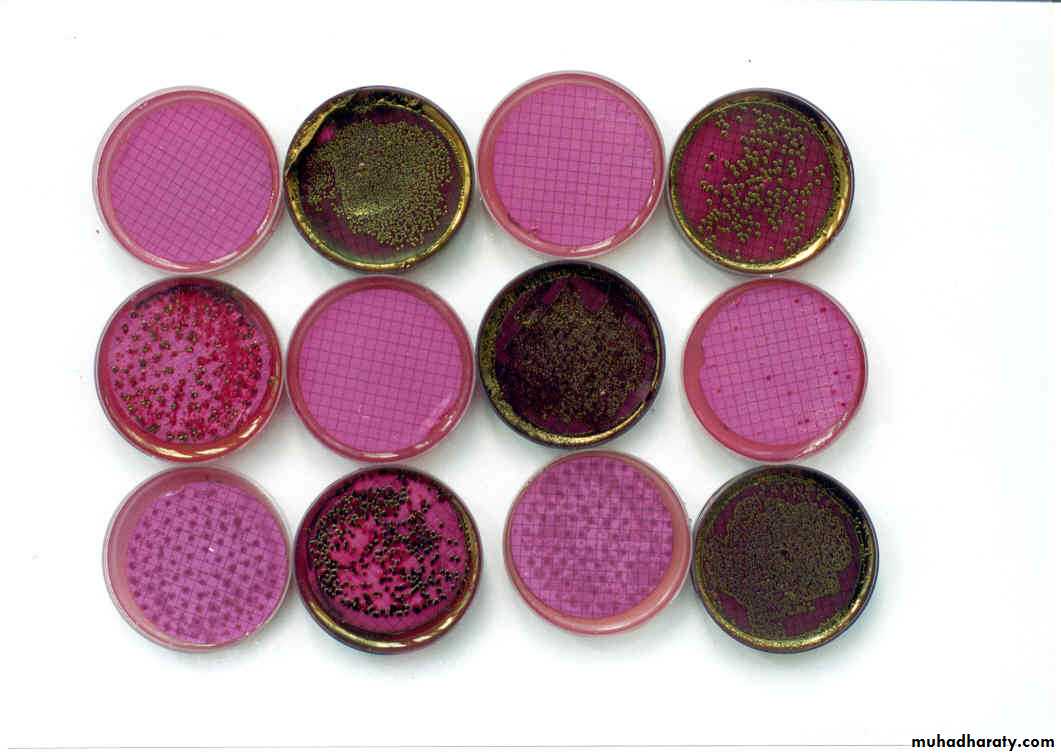

قال تعالى: ) وجعلنا من الماء كل شيء حي أفلا يؤمنون (الأنبياء /30 .
تلوث الماء
هو كل ما يفسد خواصه أو يغير من طبيعته ، مما يجعله غير صالح للإنسان أو الحيوان أو النباتات.هو كل ما يفسد خواصه أو يغير من طبيعته ، مما يجعله غير صالح للإنسان أو الحيوان أو النباتات.
وذلك لسببين:
الأول : أهمية الماء وضروريته ، فهو يدخل في كل العمليات البيولوجية والصناعية ، ولا يمكن لأي كائن حي –مهما كان شكله أو نوعه أو حجمه – أن يعيش بدونه.الثاني : أن الماء يشغل أكبر حيز في الغلاف الحيوي كما أن الماء يكون حوالي( 60-70% من أجسام الأحياء الراقية بما فيها الإنسان ، كما يكون حوالي 90% من أجسام الأحياء الدنيا ) وبالتالي فإن تلوث الماء يؤدي إلى حدوث أضرار بالغة ذو أخطار جسيمة بالكائنات الحية
أنواع تلوث المياه ما يلي :-
الملوثات الفيزيائية:- وهي الملوثات التي يمكن إزالتها بعمليات بسيطة كالترسيب .مثل ( الرمل والحصويات الناعمة)
االملوثات الكيميائية:- وهي وجود أحد العناصر الهامة من عناصر التلوث في المياه.
المواد العضوية : هيدروكربونات، الزيت، الشحوم ، المبيدات الحشرية.
المواد اللاعضوية : القلويات ، المعادن الثقيلة ، الفسفور ، الكبريت.
الملوثات البيولوجية :- وتعتبر من اهم انواع الملوثات الموجودة في المياه وبعضها يسبب امراض خطيرة. مثل:-
الحيوانات الميتة : القطط الميتة.
النباتات : اوراق الاشجار.
العضويات الدقيقة: الجراثيم والديدان.
الملوثات البيولوجية :-
من أهم ملوثات المياه ما يلي :-1. مياه المطر الملوثه:- تتلوث مياه الأمطار – خاصة في المناطق الصناعية لأنها تجمع أثناء سقوطها من السماء كل الملوثات الموجودة بالهواء ، والتي من أشهرها أكاسيد النتروجين وأكاسيد الكبريت وذرات التراب.
2. مياه المجاري:- تتلوث بالصابون والمنظفات الصناعية وبعض انواع البكتيريا والميكروبات الضارة وعندما تنتقل هذه المياه الى اللينابيع وخزانات المياه فانها تلوثها.
3. المخلفات الصناعية:- وهي تشمل مخلفات المصانع الغذائية والكيمائية والألياف الصناعية والتي تؤدي إلى تلوث الماء بالدهون والبكتريا والدماء والأحماض والقلويات والأصباغ والنفط ومركبات البترول والكيماويات والأملاح السامة.
4.المفاعلات النووية:- وهي تسبب تلوثًا حرارياً للماء مما يؤثر تأثيراً ضاراً على البيئة وعلى حياتها، مع احتمال حدوث تلوث إشعاعي لأجيال لاحقة من الإنسان.
5. المبيدات الحشرية:- والتي ترش على المحاصيل الزراعية أو التي تستخدم في إزالة الأعشاب الضارة ، والتي من أشهرها مادة د .د.ت ، وبالرغم من أن هذه المبيدات تفيد في مكافحة الحشرات الضارة ، إلا أنها ذات تأثير قاتل على البكتريا الموجودة في التربة ، والتي تقوم بتحليل المواد العضوية إلى مركبات كيميائية بسيطة يمتصها النبات.
وذلك قد يؤدي إلى نوعين من التلوث :
الأول : تلوث مباشر وينتج عن الاستعمال الآدمي المباشر للحبوب والثمار الملوثة . الثاني : تلوث غير مباشر وهذا له صور شتى وطرق متعددة . 1. أن يصاب به نتيجة لتناوله للحوم الحيوانات التي تتغذى على النباتات الملوثة.
2. أن يصاب به نتيجة لسقوط هذه المبيدات في التربة وامتصاص النبات لها ، ودخولها في بناء خلايا النبات نفسه . (جمعية الإنماء الزراعية للأبقار- الخليل ).
6. التلوث الناتج عن تسرب البترول إلى البحار المحيطات:- وهو إما نتيجة لحوادث غرق الناقلات التي تتكرر سنوياً، وإما نتيجة لقيام هذه الناقلات بعمليات التنظيف وغسل خزاناتها وإلقاء مياه الغسل الملوثة في عرض البحر.
7. تلوث الأرض:- يتلوث سطح الأرض نتيجة التراكم المواد والمخلفات الصلبة التي تنتج من المصانع والمزارع والنوادي والمنازل والشوارع. (مشروع التخلص من النفايات الصلبة - جنين ).
8. الأسمدة الكيماوية :- من المعروف أن الأسمدة المستخدمة في الزراعة تنقسم إلى نوعين :
* الأسمدة العضوية : وهي تلك الناتجة من مخلفات الحيوانات والطيور والإنسان ، ومما هو معروف علمياً أن هذه الأسمدة تزيد من قدرة التربة على الاحتفاظ بالماء . *الأسمدة غير العضوية : وهي التي يصنعها الإنسان من مركبات كيميائية فإنها تؤدي إلى تلوث التربة بالرغم من أن الغرض منها هو زيادة إنتاج الأراضي الزراعية.
التــــلوث البـــــــــــــرازي
إن أي كائن حي دقيق لا يوجد بشكل طبيعي إلا في البراز سواء كان من البكتيريا أو غيرها ويعتبر وجوده في المياه مؤشر قوي على وصول البراز بشكل أو بآخر للماء وبالتالي فإن احتمال وصول الكائنات الممرضة المنقولة بالبراز إلى الماء أمر غير مستبعد.و يعتبر التلوث البرازي في المياه خطراً حقيقياً على الصحة إذ أن هذا التلوث سواءاً كان مصدره بشرياً أو حيوانياً قد يتسبب في انتقال كـائنات دقيقة ممرضة للإنسان . نسمع أحياناً عن تفشي أمراض فيروسية منقولة بالماء في بعض القرى أو الأحياء مثل التهاب الكبد،نظراً لأن الفيروسات كائنات دقيقة ممرضة إجبارياً قاد ذلك إلى فهم أن هذه الفيروسات لا تطرح إلا من المرضى وعليه فإن تلوث المياه بالفيروسات سببه وصول مخلفات المرضي المحملة بالفيروسات إلى المصادر المائية. ( كسر خط مجاري أثناء تمديد خط هاتف تحت الأرض – مخيم الفوار)
الوقاية من التلوث البرازي:
التأكد من مصدر المياه سواء كانأ. من التنكات المتنقلة اوالوصلات. (تلوث بعض الينابيع وعيون المياه-الخليل ، المنزل القديم) .
ب. مياه الجمع .
اعتبارات تسبق حفر بئر او بناء خزان:-
كمية المياه المراد تخزينها.مدة حفظ المياه في البئر أو الخزان.
موقع حفر البئر أو الخزان.(أن يكون بعيدا عن شبكات الصرف وحفر المجاري الامتصاصية 15 م على الأقل).
إمكانية تنظيف البئر أو الخزان بشكل دوري.
الهدف من حفظ وتجميع المياه.
أفضل الطرق لجمع مياه الأمطار
• أن يكون السطح مستويا بحيث لا تتجمع المياه على شكل برك.• أن يكون بعيدا عن مصادر التلوث، محميا من وصول الحيوانات إليه.
• أن لا يكون مستخدم كممر آو مكان لعب للأطفال.
• إذا استخدم السطح لنشر الغسيل أو بعض الاستخدامات الأخرى يجب غسله جيدا وصرف المياه بعيدا عن البئر أو الخزان.
• غسل السطح قبل السماح لمياه المطار من الوصول إلى البئر أو الخزان.
أفضل الطرق لجمع مياه الأمطار
• أن يكون السطح بدرجة ميلان مناسبة (1.5 % متبع في فلسطين).• أن يكون السطح محاطا بسور مرتفع عن مستوى السطح ( 25-6- سم).
• أن يكون السطح مستويا بحيث لا تتجمع المياه على شكل برك.
• أن يكون بعيدا عن مصادر التلوث، محميا من وصول الحيوانات إليه.
• أن لا يكون مستخدم كممر آو مكان لعب للأطفال.
• إذا استخدم السطح لنشر الغسيل أو بعض الاستخدامات الأخرى يجب غسله جيدا وصرف المياه بعيدا عن البئر أو الخزان.
• غسل السطح قبل السماح لمياه المطار من الوصول إلى البئر أو الخزان.
كيفية الكشف عن التلوث البرازي:-
• الاسهال
• التقيوء
• وجع في البطن ( المغص)
كيفية معالجته( الكـلـــــورة):-
في حالة الكشف عن الكولونيات.تستخدم مادة هيبوكلورايت الكالسيوم في تطهير آبار جمع مياه المطر أو حيث تقتضي الضرورة وذلك بعدة طرق:-
1. اضافة الكلور (السائل والغازي) : يتم في محطات خاصه في شبكة المياه من قبل البلديات وسلطة المياه.
2. اضافة الكلور (الصلب) : يتم ذلك بعد طحنه واذابته في وعاء ماء، ثم يضاف الى الخزان او البئر ويحرك جيدا ويمنع الشرب منه الا بعد مرور 24 ساعة .
اما الماءالذي يحتوي على الكولونيات الاشريكية (Fecal Coliform)، فيجب التخلص منه ومعالجة مصدر التلوث البكتيري.
عزل المياه في خزان خاص ومعالجته على حدى.
فعالية و تأثير الكلورة على الكولونيات
تستخدم الكلورة بشكل شائع لتطهير المياه حيث يعول على نواتج تفاعل الكلور مع الماء في إحداث نوعين من الضرر للخلايا البكتيرية:-1. أن يمزق الغشاء الخلوي البكتيري مما يفقده خاصيته شبه المنفذة و يدمر بذلك وظائف الخلية الأخرى، ويؤدي تدمير الأغشية الخلوية إلى فقدانها بروتينات (DNA )و ( RNA) مما يقود إلى موت هذه الخلايا.
2. يدمر أيضاً الأحماض النووية البكتيرية والبروتينات، وبالنسبة للفيروسات فإن أسلوب عمل الكلور على الفيروسات يعتمد على نوع الفيروس حيث يدمر الحمض النووي وهي الخطوة الأولى في إيقاف بعض الفيروسات، بينما يعمل الكلور على تدمير الغطاء البروتيني لفيروسات.
أين يمكن إجراء الفحوصات ؟؟؟؟!!!وحدة ابحاث الطاقة البديلة والبيئة
تأسست وحدة أبحاث الطاقة البديلة والبيئة في منتصف العام 1999 نتيجة لحاجة الوطن لمركز بحثي متخصص ويمكن من خلاله توفير التخصصات المختلفة والمتنوعة التي توجد في
جامعة بوليتكنيك فلسطين.
وتسعى الوحدة إلى تعزيز استخدام المصادر المتجددة والمتنوعة للطاقة النظيفة. إضافة إلى تشجيع واستحداث برامج ترشيد الطاقة والمساهمة في إيجاد التقنيات التي تساهم في رفع كفاءة أنظمة الطاقة مع الحفاظ على البيئة. وعلى صعيد البيئة فان الوحدة قامت على أساس توفير البنية التحتية اللازمة لفحص عناصر البيئة كون هذا يعتبر الأساس للبحث العلمي والتطوير. وللمساهمة في التطوير العلمي المستدام فان الوحدة تقوم بتطوير برامج بناء القدرات على المستوى الوطني في مختلف التخصصات الحيوية في الطاقة والبيئة.
• مختبر المياه الذي والذي يمكن فيه قياس:
• 1. القولونيات الكلية Total Coliforms• 2. والإشريكية القولونية Escherichia Coliforms.
• 3. وكذلك فحص جودة المياه كيميائيا ويتم فحص عينات مياه في المختبر للمعنيين بأسعار رمزية.
ظاهرة الطفل الأزرق
العديد من الملوثات الكيميائية يمكن أن تصل بشكل أو بأخر إلى مياه الشرب مشكلة بذلك خطرا صحياً يهدد المستهلكين لهذه المياه و يعتمد في خطورته على عدة عوامل مثل تركيز الملوث ونوع الأثر الصحي الذي يسببة بفعل خصائصة الكيميائية وتداخلها مع وظائف الجسم البشري أو قدرته على التراكم ودرجة التعرض للملوث و طريقة تعاطيه واخرى تتعلق بالإنسان ........الخيعد تلوث مياه الشرب بالنيتريت NO2 من الحالات الشائعة في العديد من المناطق للإرتباط الشديد بين هذا الملوث والعديد من الأنشطة البشرية المتعلقة بالزراعة والتخصيب أو التصنيع او بالمخلفات السائلة وغير ذلك حيث يعد النيتريت من أشهر صور النيتروجين في الماء خاصة وأن العديد من الأجناس البكتيرية والموجودة غالبا في الماء إما بشكل طبيعي أو على خلفية تلوث ميكروبي لها القدرة الأنزيمية على تحويل بعض صور التلوث بمركبات النيتروجين إلى نيتريت،بل إن البكتيريا في بطن الطفل الرضيع قد تكون مسؤلة عن تحويل النترات التي يتعاطاها مع الماء إلى مركبات مؤكسدة قوية تستطيع أن تؤكسد الحديد في هيموجلوبين كريات الدم الحمراء مما ينتج عنه خفض شديد لقدرتها على حمل الأكسجين مؤدية بذلك إلى ظهور أعراض تشمل الغثيان والإستفراغ والدوخةو الصداع والأنيميا أو الزرقة في الجلد.كما يمكن للنيتريت أن تتحول في بطن الإنسان الى مركبات مسرطنة مثل النيتروزأمين والنيتروز هكسا ميثيل أمين و خلافة .الجهات المعنية بالتقييس في العديد من الأماكن قد اشترطت لجودة المياه المعدة للشرب حدا اعلى للنيتريت فيها لا يتجاوز 10ميكروجرام في اللتر .
حقائق وأرقام
نتائج الفحوصات التي قامت بها الوحدة لبعض المناطق في محافظة الخليلجدول يبين الخصائص الحيوية لمياه الشبكة الداخلية والخزانات
• الرقم
• المنطقة• المعيار العالمي
• عدد الخزانات
• الخزانات الملوثة بالقولونيات
• المجموع
• نسبة التلوث
• %
• الكلية
• الإشريكية• 1
• حي الجامعة• <2
• 36
• 5
• 3
• 8
• 22
• 2
• واد الهرية
• <2
• 36
• 6
• 3
• 9
• 25
• 3
• م. الصناعية
• <2
• 36
• 3
• 2
• 5
• 14
• 4
• قرية تفوح
• <2
• 28
• 6
• 3
• 9
• 32
• 5
• مخيم الفوار
• <2
• 36
• 6
• 2
• 8
• 22
• المجموع
• 172
• 25
• 13
• 39
• 23
جدول يبين الخصائص الحيويةلآبار الجمع
• الرقم
• المنطقة• المعيار العالمي
• عدد الخزانات
• الخزانات الملوثة بالقولونيات
• المجموع
• نسبة التلوث• %
• الكلية
• الإشريكية• 1
• حي الجامعة• <2
• 36
• 5
• 4
• 9
• 25
• 2
• واد الهرية
• <2
• 36
• 7
• 5
• 12
• 33
• 3
• م. الصناعية
• <2
• 18
• 2
• 1
• 3
• 17
• 4
• قرية تفوح
• <2
• 36
• 9
• 7
• 16
• 44
• 5
• مخيم الفوار
• <2
• 14
• 2
• 2
• 4
• 29
• المجموع
• 140
• 25
• 19
• 44
• 31
جدول يبن بعض العناصر الكيميائية والقيمة المسموح بها في مياه الشرب
• Unit
• Values
• Element
• No.
• count per 100 mL
• 0 #/100 mL
• Total coliform bacteria
• 1
• count per 100 mL
• 0 #/100 mL
• Faecal coliform bacteria
• 2
• mg/L
• 0.2
• Aluminum
• 3
• mg/L
• 50
• Ammonia
• 4
• mg/L
• 100
• Calcium
• 5
• mg/L
• 250
• Chloride
• 6
• mg/L
• >0.5
• Chlorine (total residual in chlorine-disinfected water
• 7
• mg/L
• >0.1
• Chlorine (free residual
• 8
• mg/L
• 1
• Copper
• 9
• mg/L
• 1.5
• Fluoride
• 10
• mg/L
• 0.3
• Iron
• 11
• mg/L
• 0.01
• Lead
• 12
• mg/L
• 200
• Magnesium
• 13
• mg/L
• 0.05
• Manganese
• 14
• mg/L
• 0.001
• Mercury
• 15
• mg/L
• Nitrate
• 16
• mg/L
• Nitrite
• 17
• pH
• 18
• mg/L
• 200
• Sodium
• 19
• mg/L
• 500
• Sulphate
• 20
• mg/L
• 0.05
• Sulphide
• 21
• mg/L
• 22
جدول يبن بعض العناصر الكيميائية والقيمة المسموح بها في مياه الشرب
WHO=World Health Organization.
EU=European Union
صور تجهيزات وحدة أبحاث الطاقة البديلة والبيئة
صور فحص بعض عينات المياه
عينة ماء نظيفة
T.C. عينة ماء ملوثة بـ
F.C عينة ماء ملوثة بـ
عينات ماء نظيفة وأخرى ملوثة جرثوميا
المراجع1. وحدة أبحاث الطاقة البديلة والبيئة.
2.الشبكة الدولية للمعلوماتية (الانترنت).
3. مشروع التوعية البيئية.
للاتصال
د. عماد الخطيبم. مهند عبد الله نصار
وحدة أبحاث الطاقة البديلة والبيئة
جامعة بوليتكنيك فلسطين ، ص.ب. 198 الخليل ، تلفاكس: 2233050-02